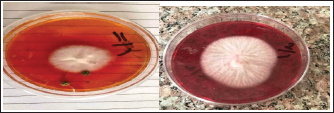

| Research Article | ||
Open Vet. J.. 2025; 15(5): 2081-2086 Open Veterinary Journal, (2025), Vol. 15(5): 2081-2086 Research Article Prevalence of dermatophyte infections in cats in Ramadi and Fallujah Cities, IraqMohammed Ali Hussein*, Khalid Ismael Oleiwi and Omar Attalla FahadDepartment of Internal and Preventive Medicine, College of Veterinary Medicine, University of Fallujah, Fallujah, Iraq *Corresponding Author: Mohammed Ali Hussein. Department of Internal and Preventive Medicine, College of Veterinary Medicine, University of Fallujah, Iraq. Email: mohammedalani [at] uofallujah.edu.iq Submitted: 27/01/2025 Revised: 08/04/2025 Accepted: 15/04/2025 Published: 31/05/2025 © 2025 Open Veterinary Journal
ABSTRACTBackground: Dermatophytosis, which is characterized by superficial infection of keratinized tissues, is the most frequent fungal disease in small animal veterinary medicine. Diagnosing dermatophytosis purely according to clinical indications is problematic because dermatological findings vary, and various other skin diseases resemble the characteristic fungal lesion. Aim: This study aimed to detect the prevalence of dermatophytes in pet cats with skin lesions who presented to private veterinary clinics in Ramadi and Fallujah cities, Iraq. Methods: The current research presents the laboratory findings of an extensive survey examining the fungal etiology of skin disorders by analyzing skin-scraping specimens from cats with clinical suspicion of dermatophytosis. Samples were collected from one hundred and thirty-six cats (n=136) in several veterinary clinics in Ramadi and Fallujah, and presented with a case history of skin lesions from early February 2023 until the end of December 2024. All cats were checked using Wood’s Lamp U.V. light pin, and direct microscopic examination and fungal culture were performed using Dermatophytes Test Media DTM. Results: All samples showed positive results for the Wood’s Lamp test; the percentage of positive dermatophyte specimens was 64 [47%]. Microsporum canis was identified in all cultures that tested positive for dermatophytes and was the most common fungus species in cats. Conclusion: The study concluded that dermatophytes are highly prevalent in crossbreeds, males, and young animals, and high infection rates are reported in the winter season. Keywords: Dermatophytes, Microsporum, Cat, Fungi, Prevalence IntroductionDermatophytosis is an integumentary, cosmopolitan mycotic infection that occurs in 145 countries worldwide and is sporadic and epidemic. It is significant from an economic and public health perspective (Murmu et al., 2015). Dairymen, animal handlers, cattle producers, pet owners, veterinarians, and others are susceptible to this significant occupational fungal infection (Ruben, 2010). Although there are over 30 known species of dermatophytes, the three primary genera Trichophyton, Microsporum, and Epidermophyton are the ones most commonly linked to ringworm (Mattei et al., 2014). T. verrucosum, T. mentagrophytes, and M. canis are dermatophyte species found all over the world. Microsporum canis is a pathogenic fungus that is considered a zoophilic dermatophyte (Aasi and Al-Aaraji, 2018) that invades the keratinized structures of cats, causing clinical conditions often marked by itching, circular lesions, multifocal alopecia, and Scaling (Mao et al., 2014). Extracellular proteases are pathogenic fungi’s primary virulence factors; their proteolytic activities are critical in collecting nutrients from the external environment, eliminating host barriers and defenses, and affecting host homeostasis (Satala et al., 2023). Although more than 30 dermatophyte species exist, the ringworm is most frequently associated with three main genera: Trichophyton, Microsporum, and Epidermophyton (Mattei et al., 2014). Globally distributed dermatophyte species include Microsporum canis, T. verrucosum, and T. mentagrophytes. Different regions worldwide have shown significant rates of superficial mycoses from zoophilic dermatophytes (Akpolat et al., 2005). India has presented such infections in its humid climate and unsanitary conditions, according to Weese and Fulford (2010). Nearly 20%–50% of human skin diseases are caused by zoonotic dermatophytes, which are primarily prevalent in pets and may spread to other species (Trichophyton mentagrophytes and Microsporum canis) (Scott et al., 2001). More than 50%–70% of human mycotic infections are caused by animal hosts, primarily pet (Day et al., 2012; Moretti et al., 2013). Regardless of age, improper pet care may lead to a rise in the number of sick pets (Day et al., 2012), which can then lead to human infection where the bacteria colonize the keratinized outermost layer of the skin and cause serious lesions (Moretti et al., 2013). Various studies have documented that the prevalence of dermatophytoses worldwide ranges from 4% to 20% in dogs and more than 20% in cats (Mattei et al., 2014; Moriello et al., 2017). In Iraq, many studies have investigated fungal infections in cats (Hasso, 2007; Al-Tae, 2017; Minnat and Khalf, 2019; Ali and Yassein, 2022; Jarjees and Issa, 2022). This study aimed to detect the prevalence of dermatophytes in pet cats with skin lesions who presented to private veterinary clinics in Ramadi and Fallujah cities, Iraq. Materials and MethodsFrom early February 2023 until the end of December 2024, a survey was conducted at four veterinary clinics in Ramadi and Fallujah that handled pet animals. Data were collected from 136 cats with skin lesions and hair loss. Data on age, sex, breed, previous treatment, and use of fungus vaccination were recorded using a questionnaire. Skin-scraping samples were collected from each animal and stored in clean plastic containers. The samples were then kept in a cooling box and transported to the clinical pathology laboratory of Fallujah University Veterinary College. Using a Wood’s Lamp Ultraviolet (UV) light pin, animals were examined to detect dermatophyte arthrospores on the hair coat (Fig. 1). Laboratory examinations of samples were performed using direct microscopic examination for skin scraping samples and fungal culture using Dermatophytes Test Media DTM (HiMedia, India, REF: M188-500G) (Fig. 2).
Fig. 1. Wood’s Lamp ultraviolet (U.V.) light pin. Following inoculation, the plates were incubated for 2 weeks at 27 °C. The plates were checked for fungal growth twice a week, and samples were deemed negative if there was no growth in week 4. The first step in identifying the cultures of the isolated dermatophytes was to examine their microscopic features and colony morphologies (macroscopically) on DTM. Dermatophytes create alkali chemicals that raise pH and turn the medium’s phenol red from yellow to red; thus, they were recognized by the change in DTM color from yellow to red. Lactophenol cotton blue stain (LPCB) and adhesive tape were used to identify the isolates. After coating the slide with LPCB, a sticky tape containing fungal structures was attached. Ethical approvalThis study was approved by the Ethics Committee of the College of Veterinary Medicine, University of Fallujah. ResultsConsidering the significance of M. canis infestation in cats and the level of damage they inflict, this study was conducted to determine the prevalence of M. canis in pet cats (Felis catus) in Ramadi and Fallujah Cities. More than 500 million cats are kept as pets worldwide because of their delicate nature, pleasant learning, and sense of essence (Seidensticker and Lumpkin, 2016). All examined cats showed positive results on Wood’s Lamp pin U.V. light examination (Fig. 3).
Fig. 2. Dermatophytes test media DTM (manufactured by HiMedia).
Fig. 3. Examination of a cat using a Wood’s Lamp U.V. pin light.
Fig. 4. Dermatophytes colonies on DTM. Fungal sample culture on DTM.
Fig. 5. Microsporum canis forms spindle-shaped macroconidia with thick walls and a knob at the terminal end. Table 1. Prevalence of dermatophytosis according to the season.
Table 2. Distribution of positive dermatophyte cases according to breed.
Figure 4 shows two Petri dishes with dermatophyte colonies cultivated on DTM. LPCB and sticky tape were used to identify the isolates. Figure 5 shows Microsporum canis produces spindle-shaped macroconidia with thick walls and a knob at the terminal end based on the morphological description of the macroconidia shape mentioned. The results of the current study showed that the total infection rate of cat dermatophytosis was 47% (64 out of 136): the seasonal prevalence was found to be 39% in winter, while it was lower in autumn, with an infection prevalence of 12.5%. These are statistically non-significant results at p < 0.05, as shown in Table 1. The dermatophyte infection rate according to breed distribution in this study revealed the highest infection rate in crossbreeding (42.2%), while the lowest infection rate was in the local breed (3.1%) (Table 2). The prevalence of dermatophytes according to the sex of the animal showed a higher percentage in males (67.2%) than in females (32.8%) (Table 3). Depending on the age group of animals included in this study, the results illustrated that cats younger than 1 year had a higher infection rate (84.4%), whereas cats older than 1 year had a lower incidence rate (15.6%) (Table 4). Table 3. Distribution of positive dermatophyte cases according to sex.
Table 4. Distribution of positive cases of dermatophytes according to age.
DiscussionThe results of the current study showed that the total infection rate of cat dermatophytosis was 47% (64 out of 136): Nweze (2011) also supported this high rate of prevalence in cats, and Esch and Peterson (2013) observed 58%–67% occurrence rate in their studies, (55.5%) (Murmu et al., 2015). In Kurdistan, Iraq, Jarjees and Issa (2022) discovered that M. canis was the most common isolate (95.24%) of dermatophytes from cats, with an isolated rate of 44.36%. One of the leading causes of dermatophyte infections in both humans and animals is the zoophilic dermatophyte Microsporum canis (Rad et al., 2018; Chupia et al., 2022). Other specialists believe that fungal skin infections in veterinary medicine are overdiagnosed (Moriello, 2004). Based on studies on the causes of skin diseases in cats using fungal cultures, the frequency of dermatophytes may be limited to all dermatological cases (Foil, 1990). Falahati et al. (2003) and Mattei et al. (2003) stated that M. canis is a dermatophyte that infects humans and animals by >60%. This study affirms that M. canis is the most frequent species of infection in cats and dogs, followed by M. gypseum and T. mentagrophytes (Bridhante et al., 2003) and Seker and Dogan (2011). Dermatophytosis infection was recognized to be more prominent in winter, with a prevalence of 39%, whereas it was less prominent in autumn, with a prevalence of 12.5%. These are statistically nonsignificant results at p < 0.05, as shown in Table 1. The chi-square statistic is zero, and the p-value is 1, indicating that there is no significant difference between the observed and expected distribution of cases across the seasons. Essentially, the prevalence of dermatophytosis does not vary significantly by season based on these data. The effect of season on the infection rate of dermatophytes was higher in winter and spring than in autumn. This could be related to the impact of the year season, climate, temperature, humidity, health of the cat, stress factors, number of spores, and hygiene on the prevalence of infection (Minnat and Khalf, 2019). Infection is significantly influenced by season. One factor that might increase the likelihood of dermatophyte infections is the wet winter months. Furthermore, weather variations significantly impact the cleanliness of cats’ bodies since owners refrain from walking their pets out of concern for diseases that might lead to skin infections or other abnormalities. The current results of the breed’s infection rates are in agreement with the previous study by Saleem et al. (2020), who found that a high prevalence of M. canis infestation was recorded in Persian cats, whereas the lowest prevalence of M. canis was recorded in the local breed (21.05%). Other researchers have found a higher prevalence in other breeds (Moriello and DeBoer, 1995; Cabañes et al., 1997; Puls et al., 2018). High infection rates were variable among different breeds because long-haired coat breeds trap more spores and have fungal-friendly environments than short-haired cats. Local breeds had the lowest prevalence because they are more immunologically competent than exotic breeds (Saleem et al., 2020). The effect of breed on this outcome may be explained by the aggressive behavior of males, which may cause injuries and abrasions of the skin, which is a predisposing factor to infections with dermatophytes (Frymus et al., 2013). However, the incidence of fungal skin infections in male and female cats did not differ significantly, according to research by Brilhante et al. (2003), Falahati et al. (2003), and Seker and Dogan (2011). Nonetheless, this result is consistent with a slightly greater prevalence of dermatophytoses in male cats, as Alpun and Ozgur (2009) described. In line with the findings of Falahati et al. (2003) (65.7% in males and 34.4% in females) and Ngwogu and Otokunefor, (2007) (29% in males and 1.4% in females), male patients were more affected than female patients. This may be because males are more likely to be associated with suffering pets. It is important that the rainy season has noticeably higher infection rates than other seasons because this corresponds with Falahati et al. (2003) and Maraki et al. (2012). According to the study, animals younger than one year were most impacted, which is consistent with other research (Minnat and Khalaf, 2019; Zaki et al., 2021). Moriello et al. (2017) reported that young animals are more vulnerable to dermatophytosis because of their immaturity, prior immunity, and skin microtrauma from ectoparasites or siblings. ConclusionAccording to the current study, fungal infections are most common in winter. M. canis is the main pathogen that infects vulnerable hosts of all ages. Therefore, taking appropriate precautions while caring for pets is important to reduce the risk of human infection. AcknowledgmentsSpecial thanks to the College of Veterinary Medicine, University of Fallujah. FundingNo funding. Author contributionMohammed Ali Hussein: Writing and editing. Khalid Ismael Oleiwi: practical work. Omar Attalla Fahad: sample collection. Conflict of interestThe authors declare no conflict of interest. Data availabilityData available upon request. ReferencesAasi, S.R. and Al-Aaraji, A.M. 2018. The inhibitory effect of Trichoderma harzianum CA-07 crude extract against Trichophyton mentagrophyte and Microsporium canis. Iraqi J. Sci. 1387–1395. Akpolat, N.O., Akdeniz, S., Elci, S., Atmaca, S. and Ozekinci, T. 2005. Tinea capitis in Diyarbakir, Turkey. Mycoses 48(1), 8–10. Ali, N.M. and Yassein, S.N. 2022. Isolation and identification of Microsporum Canis from pet animals of Baghdad Province. Proc. First Int. Conf. Adv. Res. Pure Appl. Sci. 2398, 1040044–1040048. Alpun, G. and Ozgur, N.Y. 2009. Mycological examination of Microsporum canis infection in suspected dermatophytosis of owned and ownerless cats and its asymptomatic carriage. J. Anim. Vet. Adv. 8(4), 803–806. Brilhante, R.S.N., Cavalcante, C.S.P., Soares Jr,, F.A., Cordeiro, R.A., Sidrim, J.J.C. and Rocha, M.F.G. 2003. High rates of Microsporum canis, feline, and canine dermatophytoses in Northeast Brazil: epidemiological and diagnostic features. Mycopathologia 156, 303–308. Cabanes, F.J. 2000. Dermatophytes in domestic animals. Rev. Iberoamer. Micol. 17, 104–108. Chermette, R., Ferreiro, L. and Guillot, J. 2008. Dermatophytoses in animals. Mycobatologia 166, 385–405. Chupia, V., Ninsuwon, J., Piyarungsri, K., Sodarat, C., Prachasilchai, W., Suriyasathaporn, W. and Pikulkaew, S. 2022. Prevalence of Microsporum canis in pet cats in small animal hospitals, Chiang Mai, Thailand. Vet. Sci. 9(1), 21. Day, M.J., Breitschwerdt, E., Cleaveland, S., Karkare, U., Khanna, C., Kirpensteijn, J., Kuiken, T., Lappin, M.R., McQuiston, J., Mumford, E., Myers, T., Palatnik-de- Sousa, C.B., Rubin, C., Takashima, G. and Thiermann, A. 2012. Surveillance of zoonotic infectious disease transmitted by small companion animals. Emerg. Infect. Dis. 18(12), e1. Esch, K.J. and Peterson, C.A. 2013. Transmission and epidemiology of zoonotic protozoal diseases of companion animals. Clin. Microbiol. Rev. 26(1), 58–85. Falahati, M., Akhlaghi, L., Lari, A.R. and Alaghehbandan, R. 2003. Epidemiology of dermatophytoses in an area south of Tehran, Iran. Mycopathologia 156, 279–287. Foil, C.S. 1990. Dermatophytosis. In Infectious diseases of the dog and cat. Eds., Greene, C.E. Philadelphia, PA: W.B. Saunders, 659–668. Frymus, T., Gruffydd-Jones, T., Pennisi, M.G., Addie, D., Boucraut-Baralon, S.B., Egberink, H., Hartmann, K., Hosie, M.J., Lloret, A., Lutz, H., Marsilio, F., Möstl, K., Radford, A., Thiry, E., Truyen, E. and Horzinek, M. 2013. Dermatophytosis in Cats ABCD guidelines on prevention and management. J. Feline Med. Surg. 15, 598–604. Jarjees, K.I. and Issa, N.A. 2022. First study on the molecular epidemiology of dermatophytosis in cats, dogs, and their companions in the Kurdistan region of Iraq, Vet. World 15(12), 2971–2978. Mao, L., Zhang, L, Li, H., Chen, W., Wang, H., Wu, S. and Abliz, P. 2014. The pathogenic fungus Microsporum canis activates the NLRP3 inflammasome. Infect. Immunol. 82(2), 882–892. Maraki, S. 2012. Epidemiology of dermatophytoses in Crete, Greece, between 2004 and 2010. G. Ital. Dermatol. Venereol. 147(3), 315–319. Mattei, A.S., Beber, M.A. and Madrid, I.M. 2014. Dermatophytosis in small animals. SOJ Microbiol. Infect. Dis. 2(3), 1–6. Minnat, T.R. and Khalf, J.M. 2019. Feline dermatophytosis:Epidemiological,clinical, and laboratory features in Baghdad governorate, Iraq. Biochem. Cell. Arch. 19, 4025–4033. Moretti, A., Agnetti, F., Mancianti, F., Nardoni, S., Righi, C., Moretta, I., Morganti, G. and Papini, M. 2013. Dermatophytosis in animals: epidemiological, clinical, and zoonotic aspects. Venerol. 148(6), 563–572. Moriello, A.K.A., Koynert, K., Paterson, S. and Mignon, B. 2017. Diagnosis and treatment of dermatophytosis in dogs and cats. Vet. Dermatol. 28, 266–288. Moriello, K.A. 2003. Zoonotic skin diseases in dogs and cats. Anim. Health Res. Rev. 4(02), 157–168. Moriello, K.A. and DeBoer, D.J. 1995. Efficacy of griseofulvin and itraconazole in the treatment of experimentally induced dermatophytosis in cats. J. Am. Vet. Med. Assoc. 207(4), 439–444. Moriello, K.A. 2004. Treatment of dermatophytosis in dogs and cats: review of published studies. Vet. Dermatol. 15(2), 99–107. Murmu, S., Debnath, C., Pramanik, A.K., Mitra, T., Jana, S., Dey, S., Banerjee, S. and Batabyal, K. 2015. Detection and characterization of zoonotic dermatophytes in dogs and cats in and around Kolkata. Vet. World 8(9), 1078–1082. Ngwogu, A.C. and Otokunefor, T.V. 2007. Epidemiology of dermatophytoses in a rural community in Eastern Nigeria and review of literature from Africa. Mycopathologia 164, 149–158. Nweze, E.I. 2011. Dermatophytoses in domesticated animals. Rev Inst. Med. Trop. 53(2), 95–99. Puls, C., Johnson, A., Young, K., Hare, J., Rosenkrans, K., Young, L. and Moriello, K. 2018. Efficacy of an itraconazole oral solution with an alternating-week pulse therapy regimen for the treatment of experimental Microsporum canis infection. J. Feline Med. Surg. 20(10), 869–874. Rad, B.H., Hashemi, S.J., Farasatinasab, M., Atighi, J., 2018. Epidemiological survey of human dermatophytosis due to zoophilic species in Tehran, Iran. Public Health 47(12), 1930–1936. Rogério, E., Dison, C., Cansi, R. and Demo, A. 2011. Acta scientiae veterinariae. Acta Sci. Vet. 39(3), 982. Ruben, L.M. 2010. Candidosis, a new challenge. Clin. Dermatol. 28, 178–184. Saleem, M.I., Mahmood, A.K., Qudus, A., Akbar, M., Naveed, M.T., Ahsan Nadeem, M.T. and Rehman, K. 2020. Prevalence of dermatophytosis and efficacy of antifungal agents against Microsporum canis in cats. Pure Appl. Biol. 9(1), 121–131. Satala, D., Bras, G., Kozik, A., Rapala-Kozik, M. and Karkowska-Kuleta, J. 2023. More than just protein degradation: the regulatory roles and moonlighting functions of extracellular proteases produced by pathogenic fungi for humans. J. Fungi. 9(1), 121. Scott, D.W., Miller, W.H. and Griffin, C.E. 2001. Fungal skin disease. In Small animal dermatology. Eds., Muller and Krik’s. 6th ed. Philadelphia, PA: W.B. Saunders. pp: 336–361. Seidensticker, J. and Lumpkin, S. 2016. Cats in question: the Smithsonian answer book. Washington, DC: Smithsonian Books. Seker, E. and Dogan, N. 2011. Isolation of dermatophytes from dogs and cats with suspected dermatophytosis in Western Turkey. Prev. Vet. Med. 98, 46–51. Weese, J.S. and Fulford, M., editors. 2010. Companion animal Zoonoses. New Jersey: Wiley-Blackwell. pp: 278–279. Zaki, F.H., Airin, C.M., Nururrozi, A. and Indarjulianto, S. 2021. A review: the prevalence of dermatophytosis in cats in Indonesia and Turkey. BIO Web Conf. 33, 06004. | ||
| How to Cite this Article |
| Pubmed Style Hussein MA, Oleiwi KI, Fahad OA. Prevalence of dermatophyte infections in cats in Ramadi and Fallujah Cities, Iraq. Open Vet. J.. 2025; 15(5): 2081-2086. doi:10.5455/OVJ.2025.v15.i5.25 Web Style Hussein MA, Oleiwi KI, Fahad OA. Prevalence of dermatophyte infections in cats in Ramadi and Fallujah Cities, Iraq. https://www.openveterinaryjournal.com/?mno=239902 [Access: January 25, 2026]. doi:10.5455/OVJ.2025.v15.i5.25 AMA (American Medical Association) Style Hussein MA, Oleiwi KI, Fahad OA. Prevalence of dermatophyte infections in cats in Ramadi and Fallujah Cities, Iraq. Open Vet. J.. 2025; 15(5): 2081-2086. doi:10.5455/OVJ.2025.v15.i5.25 Vancouver/ICMJE Style Hussein MA, Oleiwi KI, Fahad OA. Prevalence of dermatophyte infections in cats in Ramadi and Fallujah Cities, Iraq. Open Vet. J.. (2025), [cited January 25, 2026]; 15(5): 2081-2086. doi:10.5455/OVJ.2025.v15.i5.25 Harvard Style Hussein, M. A., Oleiwi, . K. I. & Fahad, . O. A. (2025) Prevalence of dermatophyte infections in cats in Ramadi and Fallujah Cities, Iraq. Open Vet. J., 15 (5), 2081-2086. doi:10.5455/OVJ.2025.v15.i5.25 Turabian Style Hussein, Mohammed Ali, Khalid Ismael Oleiwi, and Omar Attalla Fahad. 2025. Prevalence of dermatophyte infections in cats in Ramadi and Fallujah Cities, Iraq. Open Veterinary Journal, 15 (5), 2081-2086. doi:10.5455/OVJ.2025.v15.i5.25 Chicago Style Hussein, Mohammed Ali, Khalid Ismael Oleiwi, and Omar Attalla Fahad. "Prevalence of dermatophyte infections in cats in Ramadi and Fallujah Cities, Iraq." Open Veterinary Journal 15 (2025), 2081-2086. doi:10.5455/OVJ.2025.v15.i5.25 MLA (The Modern Language Association) Style Hussein, Mohammed Ali, Khalid Ismael Oleiwi, and Omar Attalla Fahad. "Prevalence of dermatophyte infections in cats in Ramadi and Fallujah Cities, Iraq." Open Veterinary Journal 15.5 (2025), 2081-2086. Print. doi:10.5455/OVJ.2025.v15.i5.25 APA (American Psychological Association) Style Hussein, M. A., Oleiwi, . K. I. & Fahad, . O. A. (2025) Prevalence of dermatophyte infections in cats in Ramadi and Fallujah Cities, Iraq. Open Veterinary Journal, 15 (5), 2081-2086. doi:10.5455/OVJ.2025.v15.i5.25 |